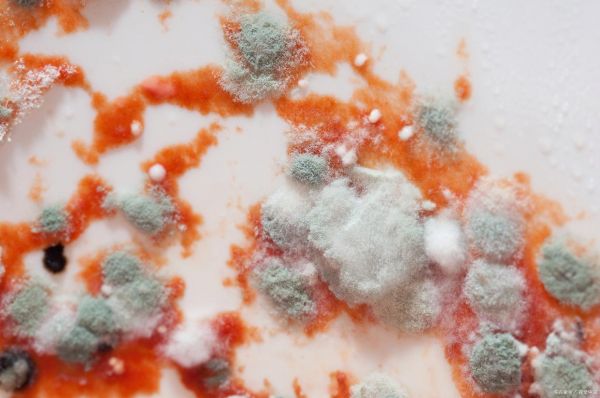
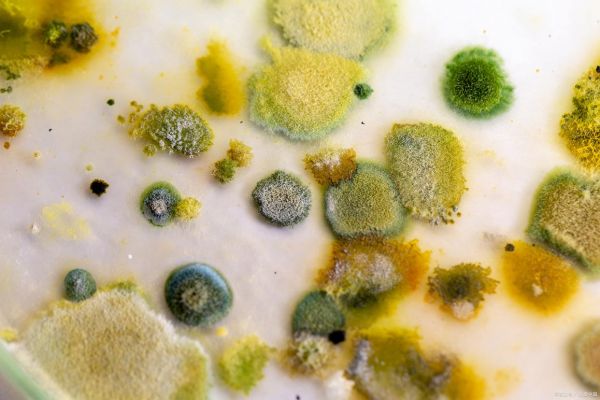
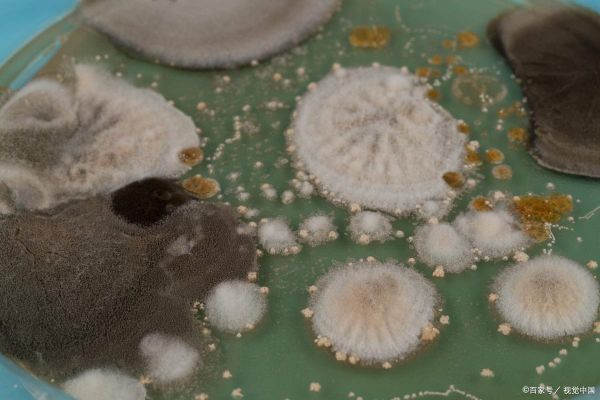

茶叶发霉:为什么不能喝?如何储存和预防发霉?
茶叶是世界上最受欢迎的饮品之一,具有丰富的文化底蕴和健康益处。然而,有一件事可能会让你大吃一惊:茶叶也会发霉!当茶叶发霉时,它不仅会失去原有的风味和香气,还可能对健康产生潜在威胁。本文将探讨茶叶发霉的原因、可能的健康风险以及如何正确储存和预防茶叶发霉。

为什么茶叶会发霉?
发霉的茶叶是由于茶叶中存在的霉菌导致的。霉菌是一种微生物,喜欢在潮湿和温暖的环境中生长。当茶叶暴露在湿度较高的环境中时,霉菌就会开始滋生。
发霉的茶叶会变质和失去风味。一旦茶叶发霉,你会闻到一种异味,这是霉菌的迹象。茶叶中的霉菌会分解茶叶的化学成分,包括茶多酚和挥发性化合物,从而导致茶叶变质。这不仅使茶叶失去原有的风味和香气,还可能引起难以忍受的霉菌味道。
而且,发霉的茶叶可能对健康产生不利影响。发霉的茶叶中可能含有一些有害的霉菌,如曲霉、黄曲霉等。这些霉菌会产生毒素,可能对人体健康产生不利影响。黄曲霉毒素可能对肝脏产生毒性作用,甚至可能致癌。

哪些茶叶容易发霉?
虽然所有茶叶都有发霉的风险,但有些茶叶比其他茶叶更容易受到霉菌的影响。以下是容易发霉的茶叶类型:
1. 黑茶
黑茶是一种后发酵茶,常温放置容易受到霉菌侵害。黑茶储存时需要特别注意湿度和通风。
2. 乌龙茶
乌龙茶对氧气、湿度和高温比较敏感,存储不当容易受到霉菌的影响。储存乌龙茶时要保持适当的湿度和通风条件。
3. 白茶
白茶对湿度和霉菌特别敏感,需要在适当的条件下存放。储存白茶时要保持干燥和通风。
4. 花茶
花茶中的花朵或草本成分较多,如果存放过于潮湿,容易受到霉菌侵害。储存花茶时要保持干燥和通风。
如何储存和预防茶叶发霉?
正确的储存和预防方法对于保持茶叶的新鲜和美味至关重要。以下是一些储存和预防茶叶发霉的方法:
1. 储存容器选择
使用具有良好密封性和保湿性的茶叶罐、罐子或密封袋来储存茶叶。这样可以避免空气和湿气进入茶叶。
2. 避免阳光直射
将茶叶储存在阴凉、干燥的地方,避免阳光直射。阳光会产生热量,增加茶叶受潮和发霉的风险。

3. 湿度控制
茶叶储存的理想湿度通常在60%至70%之间。可以使用湿度控制器或硅胶干燥剂来保持湿度适宜。在储存茶叶的容器中放置一些湿度调节剂,可以帮助控制湿度。
4. 避免异味
茶叶具有吸附异味的能力,因此应远离发出异味的物品。将茶叶存放在密封的容器中,避免与其他食物、香料或化学物品接触。

5. 分批储存
不要将大量茶叶全部存放在同一处,以免一旦某批茶叶受到污染,整批都受到影响。最好将茶叶分批储存在不同的容器中,避免交叉污染。
6. 定期检查和翻动茶叶
定期检查茶叶,确保没有发霉或受潮。轻轻翻动茶叶,以促进空气流通,防止茶叶过于潮湿。
7. 冷藏法
对于特别容易发霉变质的茶叶,如绿茶、黄茶和铁观音等,可以选择将其放入冷藏库。但要确保茶叶在密封容器中,避免吸收冰箱内的异味。



8. 避免潮湿环境
茶叶应避免存放在地下室或其他潮湿的环境中,因为潮湿会加速茶叶的发霉过程。尽量选择干燥的地方存放茶叶。
通过采取正确的储存和预防措施,你可以确保茶叶保持新鲜和美味,同时避免茶叶发霉的问题。在享用高质量茶叶的同时,保护你的健康和安全。
举报/反馈
相关知识
喝完的茶叶渣发霉怎么回事?发霉后有害吗?如何处理霉菌?
如何正确存放普洱茶以防止发霉
茶渣饼怎么保存才不会发霉
如何正确保存生普洱茶以防止发霉及常见保存误区
黑茶为什么有霉味 黑茶陈味和霉味的区别
白茶饼发霉了,发霉部分撬掉就行?别天真了,这样喝可不行!
养生茶过期两个月但未发霉还能喝吗
茶叶渣如何做肥料 发霉了还能做肥料吗?
竹制的茶叶罐发霉(竹制茶叶罐有异味怎么办)
一个老白茶没拦住,茶友竟喝坏了肚子,这种发霉的老白茶别再喝了
网址: 茶叶发霉:为什么不能喝?如何储存和预防发霉? https://www.trfsz.com/newsview1928106.html
推荐资讯
- 1发朋友圈对老公彻底失望的心情 12775
- 2BMI体重指数计算公式是什么 11235
- 3补肾吃什么 补肾最佳食物推荐 11199
- 4性生活姿势有哪些 盘点夫妻性 10428
- 5BMI正常值范围一般是多少? 10137
- 6在线基础代谢率(BMR)计算 9652
- 7一边做饭一边躁狂怎么办 9138
- 8从出汗看健康 出汗透露你的健 9063
- 9早上怎么喝水最健康? 8613
- 10五大原因危害女性健康 如何保 7828
